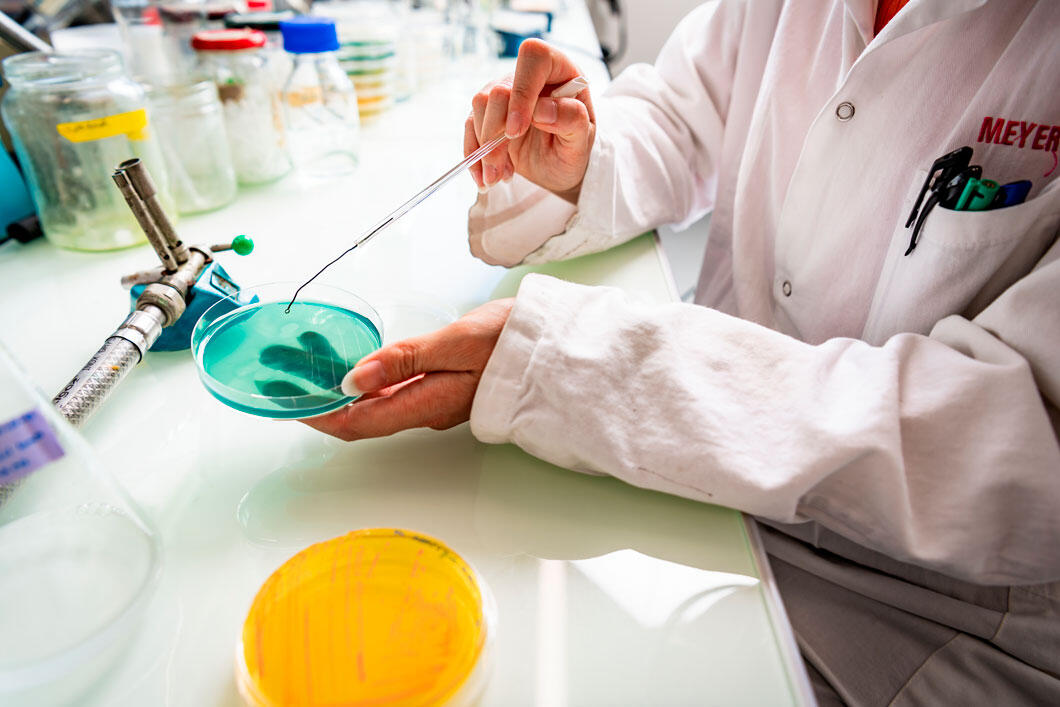
Deux boîtes de Petri, une jaune posée et une verte tenue par des mains. Le vert indique la dégradation de composés fluorés, et donc leur présence.

Vous êtes ici
Des bactéries mangeuses de PFAS
16.02.2026, par
Nombre d’objets du quotidien recèlent des PFAS, des molécules synthétiques quasi indestructibles. Mais ces milliers de composés s’accumulent dans la nature et nos organismes. L’une des pistes pour s’en débarrasser : la bioremédiation, qui élimine les polluants à l’aide d’organismes vivants.

1
Mode diaporama
L’idée de se débarrasser des PFAS (substances per- et polyfluoroalkylées, dites « polluants éternels ») grâce à des bactéries a éclos dans des laboratoires strasbourgeois. Il s’agit d’utiliser les propriétés enzymatiques* des bactéries pour briser la liaison chimique qui rend les PFAS aussi résistants à l’altération – la liaison carbone-fluor, l’une des plus fortes qui soit. Deux méthodes sont employées : la culture de bactéries en présence de PFAS sur boîte de Petri (photo) ; et le recours à la microfluidique pour réaliser cette culture dans des microgouttelettes, utilisées comme autant de tubes à essai miniatures.
*Enzyme : protéine qui, dans une cellule, facilite une réaction chimique.
Cyril Frésillon / GMGM / CNRS Images

2
Mode diaporama
Vouloir recourir aux bactéries pour dégrader des PFAS est une chose. Encore faut-il savoir lesquelles utiliser. Les chercheurs du laboratoire Architecture et réactivité de l’ARN (dirigé par Michaël Ryckelynck) se servent de puces microfluidiques moulées dans de la résine de silicone. On collecte d’abord de la terre ou de l’eau polluée aux PFAS ; puis on récupère les bactéries présentes dans ces échantillons pour les mettre en culture dans des microgouttelettes. Lesquelles seront triées par les canaux extrêmement fins (de l’ordre du micromètre, soit 0,001 millimètre) des puces.
Cyril Frésillon / ARN / CNRS Images

3
Mode diaporama
Le bloc de silicone est percé à différents endroits pour permettre le raccordement de la puce microfluidique à un appareillage dédié, notamment des tubulures qui achemineront les microgouttelettes chargées en bactéries dans les canaux de la puce. On peut ainsi analyser à haute cadence chacune de ces gouttelettes : contiennent-elles ou non des bactéries capables de produire les enzymes à même de dégrader les PFAS ?
Cyril Frésillon / ARN / CNRS Images

4
Mode diaporama
La dernière étape de fabrication de la puce microfluidique consiste à souder le bloc de résine de silicone à une plaque de verre, afin de rendre l’ensemble hermétique. Pour ce faire, le bloc de résine et la plaque sont placés dans un four à plasma pendant plusieurs minutes. Lorsque la « cuisson » est terminée, la puce microfluidique est prête à l’emploi.
Cyril Frésillon / ARN / CNRS Images

5
Mode diaporama
Vient le moment de raccorder la puce microfluidique aux tubulures. Chaque gouttelette qui y est acheminée contient bactéries et PFAS issus d’échantillons d’eau ou de sols contaminés. Les scientifiques ajoutent au milieu de culture un ARN particulier – un aptamère, capable de déceler spécifiquement la présence d’ions de fluor (fluorure).
Cyril Frésillon / ARN / CNRS Images

6
Mode diaporama
Lorsque la présence d’ions de fluor (fluorure) est décelée spécifiquement, la gouttelette devient vert fluorescent, signalant la rupture de la liaison carbone-fluor – et donc la dégradation de PFAS. Grâce à la microfluidique, les scientifiques peuvent chaque jour cribler des millions de bactéries et espérer trouver l’aiguille dans la botte de foin.
Cédric Romilly / ARN / CNRS Images

7
Mode diaporama
Une fois le tri effectué, les chercheurs approchent les gouttelettes fluorescentes d’une lampe à plasma. Le champ électrique généré par celle-ci permet de « casser » les gouttelettes et de récupérer les bactéries intéressantes.
Cyril Frésillon / ARN / CNRS Images
8
Mode diaporama
En parallèle à la microfluidique, l’approche plus classique de la culture cellulaire en boîte de Petri est utilisée au laboratoire Génétique moléculaire génomique microbiologie (GMGM, unité CNRS/Université de Strasbourg), dans l’équipe dirigée par Stéphane Vuilleumier. Des échantillons d’eau ou de sols contaminés aux PFAS sont mis en suspension dans des milieux de culture liquides pour sélectionner les bactéries potentiellement capables de les dégrader. Ces cultures sont ensuite transférées sur un milieu solide. Le gel présent dans les boîtes contient des nutriments nécessaires à la croissance des bactéries ainsi qu’un indicateur de pH. Si les bactéries cultivées se nourrissent sur ce milieu en dégradant un composé fluoré, le milieu aura tendance à s’acidifier, passant alors du vert au jaune.
Cyril Frésillon / GMGM / CNRS Images

9
Mode diaporama
Reste à confirmer si l’activité métabolique des bactéries est bien associée à la rupture de la liaison du fluor et du carbone – et donc à la dégradation de PFAS. Pour tirer cela au clair, on utilise un autre test colorimétrique. Il permet de vérifier la production de fluorure issue de cette dégradation et d’en déterminer l’intensité. Les étapes qui suivent impliquent la caractérisation et le séquençage des bactéries défluorantes, et l’identification des enzymes responsables. Le but est de pouvoir utiliser ces enzymes pour dépolluer des eaux ou des terres contaminées. La tâche s’annonce titanesque... et ne pourra aboutir qu’en combinant diverses approches de dépollution – physiques, chimiques ou biologiques.
Cyril Frésillon / GMGM / CNRS Images
Voir aussi
Vivant
Article
18/06/2026
Article
18/06/2026
Blog
11/06/2026
Vidéo
29/05/2026
Article
03/06/2026
Microbiologie
Vidéo
13/06/2018
Article
11/01/2018
Vidéo
13/03/2015
PFAS
Blog
25/03/2026










